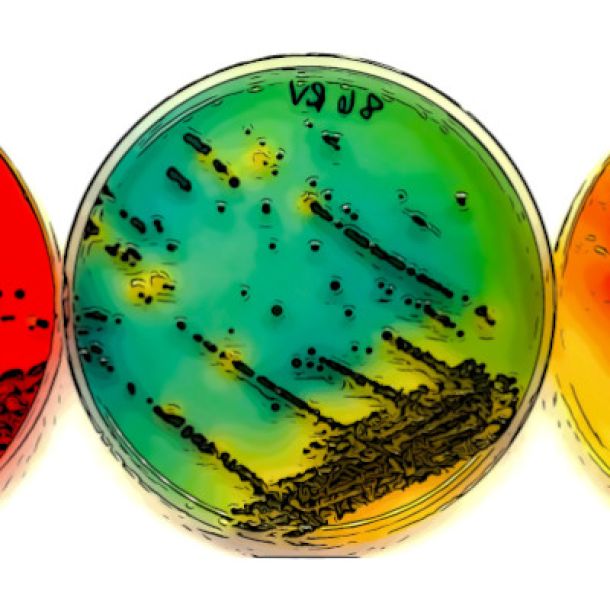

Area Video
DFM Dire Fare Mangiare 2024
L'evento di riferimento per la community della ristorazione collettiva, commerciale, tradizionale. 2gg, 28 conferenze, 45 sponsor, 200 speaker, 300 ospiti alla cena di gala, 1.500 partecipanti ai convegni. Un evento prodotto da Edifis con i team editoriali di Ristorando, retail&food, Artù. Presso Mi.Co. Milano e Palazzo Parigi, 12-13 giugno 2024 www.direfaremangiare.it